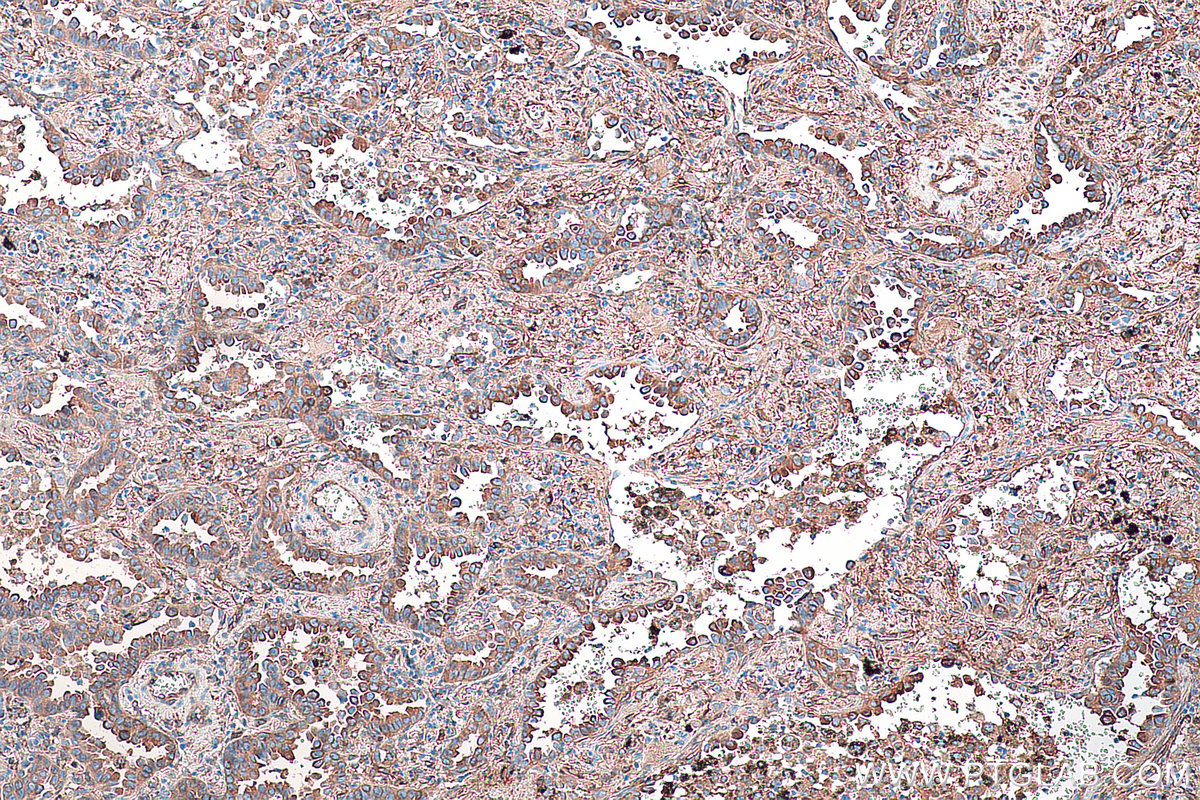

验证数据展示
产品信息
68021-1-PBS targets CRMP1 in WB, IHC, Indirect ELISA applications and shows reactivity with Mouse, Rat, Rabbit, Pig, Chicken, Human samples.
| 经测试应用 | WB, IHC, Indirect ELISA Application Description |
| 经测试反应性 | Mouse, Rat, Rabbit, Pig, Chicken, Human |
| 免疫原 |
CatNo: Ag30090 Product name: Recombinant human CRMP1 protein Source: e coli.-derived, PET28a Tag: 6*His Domain: 291-537 aa of BC000252 Sequence: WSKNWAKAAAFVTSPPLSPDPTTPDYLTSLLACGDLQVTGSGHCPYSTAQKAVGKDNFTLIPEGVNGIEERMTVVWDKAVATGKMDENQFVAVTSTNAAKIFNLYPRKGRIAVGSDADVVIWDPDKLKTITAKSHKSAVEYNIFEGMECHGSPLVVISQGKIVFEDGNINVNKGMGRFIPRKAFPEHLYQRVKIRNKVFGLQGVSRGMYDGPVYEVPATPKYATPAPSAKSSPSKHQPPPIRNLHQS 种属同源性预测 |
| 宿主/亚型 | Mouse / IgG2a |
| 抗体类别 | Monoclonal |
| 产品类型 | Antibody |
| 全称 | collapsin response mediator protein 1 |
| 别名 | CRMP 1, CRMP1, DPYSL1, DRP 1, DRP1, ULIP 3, ULIP3, Unc 33 like phosphoprotein 3 |
| 计算分子量 | 62 kDa |
| 观测分子量 | 62 kDa |
| GenBank蛋白编号 | BC000252 |
| 基因名称 | CRMP1 |
| Gene ID (NCBI) | 1400 |
| RRID | AB_2918766 |
| 偶联类型 | Unconjugated |
| 形式 | Liquid |
| 纯化方式 | Protein A purification |
| UNIPROT ID | Q14194 |
| 储存缓冲液 | PBS only, pH 7.3. |
| 储存条件 | Store at -80°C. The product is shipped with ice packs. Upon receipt, store it immediately at -80°C |
背景介绍
CRMP1 (Collapsin response mediator protein 1) is also named as DPYSL1, ULIP3, DRP-1 and belongs to the collapsin response mediator protein family, which are a family of five cytoplasmic proteins predominantly expressed in the developing nervous system. CRMP1, the predicted 62 kDa protein and its 74 kDa isoform corresponding to its N-terminal splice variant already described for embryonic, neonatal, and adult brain of the rat are evidenced in the cortex of adult mouse (PMID:15834957). This protein is involved in invasion, and aggressiveness of prolactin pituitary tumors.